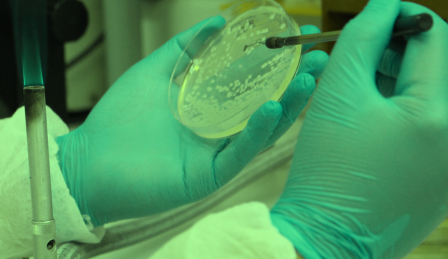

Notícias
Fique por dentro de tudo o que acontece no ILMD/Fiocruz Amazônia
PPGBIO-Interação abre processo seletivo ao Mestrado e avisa: isenção do pagamento da inscrição deve ser solicitada nos dias 20 e 21/10
Processo integra a Chamada Pública No 010/1025 e oferece 17 (dezessete) vagas, para ingresso em março de 2026

Fiocruz Amazônia divulga abertura das inscrições ao processo seletivo do Doutorado do PPGBIO-Interação Chamada 011/2025
Processo oferece 20 vagas, com percentuais destinados às ações afirmativas. O período para solicitar isenção é de 20/10 a 21/10. As inscrições iniciam em 22/10 e finalizam em 19/11/2025

Fiocruz fortalece a disseminação das primeiras capacitações em vigilância e monitoramento da exposição mercurial em populações indígenas no Brasil
Oficina inicou a construção interdisciplinar do plano de ensino, da matriz de conteúdo e do material didático que será usado nos dois cursos, a serem oferecidos para profissionais de saúde com nível superior

Fiocruz Amazônia divulga 1ª Republicação da Chamada Pública 009/2025 do PPGVIDA e informa que inscrições do processo seletivo se encerram dia 15/10
Interessados em concorrer ao processo seletivo do PPGVIDA têm até as 16h desta quarta-feira,15/10, para se inscrever.

Obsma/Fiocruz prepara programação para Semana Nacional de Ciência e Tecnologia no Amazonas
"Amazônia - o encontro do rio com o mar” é o tema que será abordado pela equipe da Coordenação Regional Norte da Obsma Fiocruz no Espaço da Cidadania Ambiental (ECAM), no Manauara Shopping, em Manaus, e no IFAM-Campus Parintins, interior do Amazonas

Fiocruz divulga resultado final do processo de seleção para o programa de pré-incubação de startups FioBiz
O processo de seleção totaliza o resultado com seis equipes selecionadas.

Coordenação nacional da Rede PROVOC destaca papel da Fiocruz Amazônia na condução de estudantes da região pelo caminho da Ciência
Equipe nacional participou de diversas atividades, a exemplo da recepção aos novos bolsistas, oportunidade na qual os alunos foram apresentados aos seus orientadores, acompanhados pelos professores apoiadores e os pais, além de encontros, em separado, com a direção da Fiocruz Amazônia, estudantes e docentes do Programa.

Fiocruz Amazônia abre as portas para uma manhã de vacinação e encontro com a Ciência em mais uma edição do Fiocruz Pra Você no próximo dia 18/10
Evento visa estimular a vacinação de crianças, jovens e adultos. Haverá também atividades lúdicas,, pintura, desenho livre, contação de histórias, intervenções artísticas e personagens infantis, que farão a alegria da garotada

Fiocruz Amazônia realiza acolhida aos bolsistas do Programa de Vocação Científica edição 2025
Atividade contará com a participação da coordenadora nacional da Rede Provoc Luiz Fernando Rocha Ferreira da Silva, Cristiane Braga, que virá especialmente a Manaus, para conhecer a turma e o trabalho desenvolvido pela coordenação do Provoc no Amazonas





